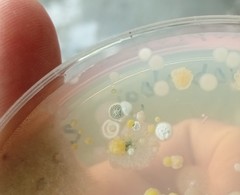
Eurotiomycetes
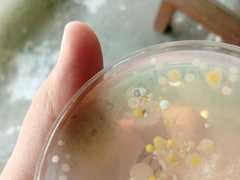
Eurotiomycetes

Eurotiomycetes: taxon details and analytics
- Domain
- Kingdom
- Fungi
- Phylum
- Ascomycota
- Class
- Eurotiomycetes
- Order
- Family
- Genus
- Species
- Scientific Name
- Eurotiomycetes
Summary description from Wikipedia:
Eurotiomycetes
Eurotiomycetes is a large class of ascomycetes with cleistothecial ascocarps within the subphylum Pezizomycotina, currently containing around 3810 species according to the Catalogue of Life. It is the third largest lichenized class, with more than 1200 lichen species that are mostly bitunicate in the formation of asci. It contains most of the fungi previously known morphologically as "Plectomycetes".
...Eurotiomycetes in languages:
- Bokmål
- kulesekksopper
- Chinese
- 散囊菌纲
- Japanese
- ユーロチウム菌綱
- Korean
- 흰가시동충하초강
- Russian
- Эвроциомицеты
Images from inaturalist.org observations:
We recommend you sign up for this excellent, free service.
Parent Taxon
Sibling Taxa
- Acaroconium
- Acarocybellina
- Acinula
- Acontium
- Acremoniella
- Acremoniula
- Alcornia
- Anungitopsis
- Aphanopsidaceae
- Arthoniomycetes
- Bahugada
- Biatoridium
- Blodgettia
- Byssocladium
- Caeruleoconidia
- Candelariomycetes
- Catenospegazzinia
- Chaetopyrena
- Collemopsidiomycetes
- Coniocybomycetes
- Coronospora
- Cremasteria
- Crinigera
- Cylindrocephalum
- Cyrtidula
- Cytoplacosphaeria
- Dactylosporium
- Desmidiospora
- Diporothecaceae
- Dothideomycetes
- Eiona
- Eopyrenula
- Eoterfeziaceae
- Epigloeaceae
- Erysiphopsis
- Eurotiomycetes
- Feltgeniomyces
- Frigidopyrenia
- Gallaicolichen
- Geoglossomycetes
- Gilmaniella
- Gloeocoryneum
- Haematomyxa
- Hapsidascus
- Harpidiaceae
- Heliscella
- Hendersonula
- Hobsoniopsis
- Imicles
- Intralichen
- Isthmolongispora
- Isthmotricladia
- Knufia
- Kolletes
- Kumanasamuha
- Laboulbeniomycetes
- Lecanoromycetes
- Lentescospora
- Leotiomycetes
- Libertiella
- Lichinomycetes
- Melanophloea
- Microxyphiella
- Milospium
- Mucomassariaceae
- Mycobacillaria
- Mycocentrodochium
- Mycoderma
- Mycosylva
- Myxothyrium
- Neopodoconis
- Nigrolentilocus
- Nypaella
- Octopodotus
- Orbiliomycetes
- Orbimyces
- Parapericoniella
- Perisporiaceae
- Pezizomycetes
- Phaeoblastophora
- Phialophorophoma
- Plectronidium
- Pleurodesmospora
- Pleurophomopsis
- Psammina
- Pyrenocollema
- Pyxidaria
- Quadracaea
- Raciborskiomyces
- Robillarda
- Saccardiaceae
- Sarcophoma
- Sareomycetes
- Sclerophoma
- Seuratiaceae
- Siroplacodium
- Sordariomycetes
- Spermatoloncha
- Stanhughesiella
- Stauronematopsis
- Stigmella
- Strangosporaceae
- Thelocarpales
- Trullula
- Volucrispora
- Wadeana
- Wojnowicia
- Xylobotryomycetes
- Xylonomycetes